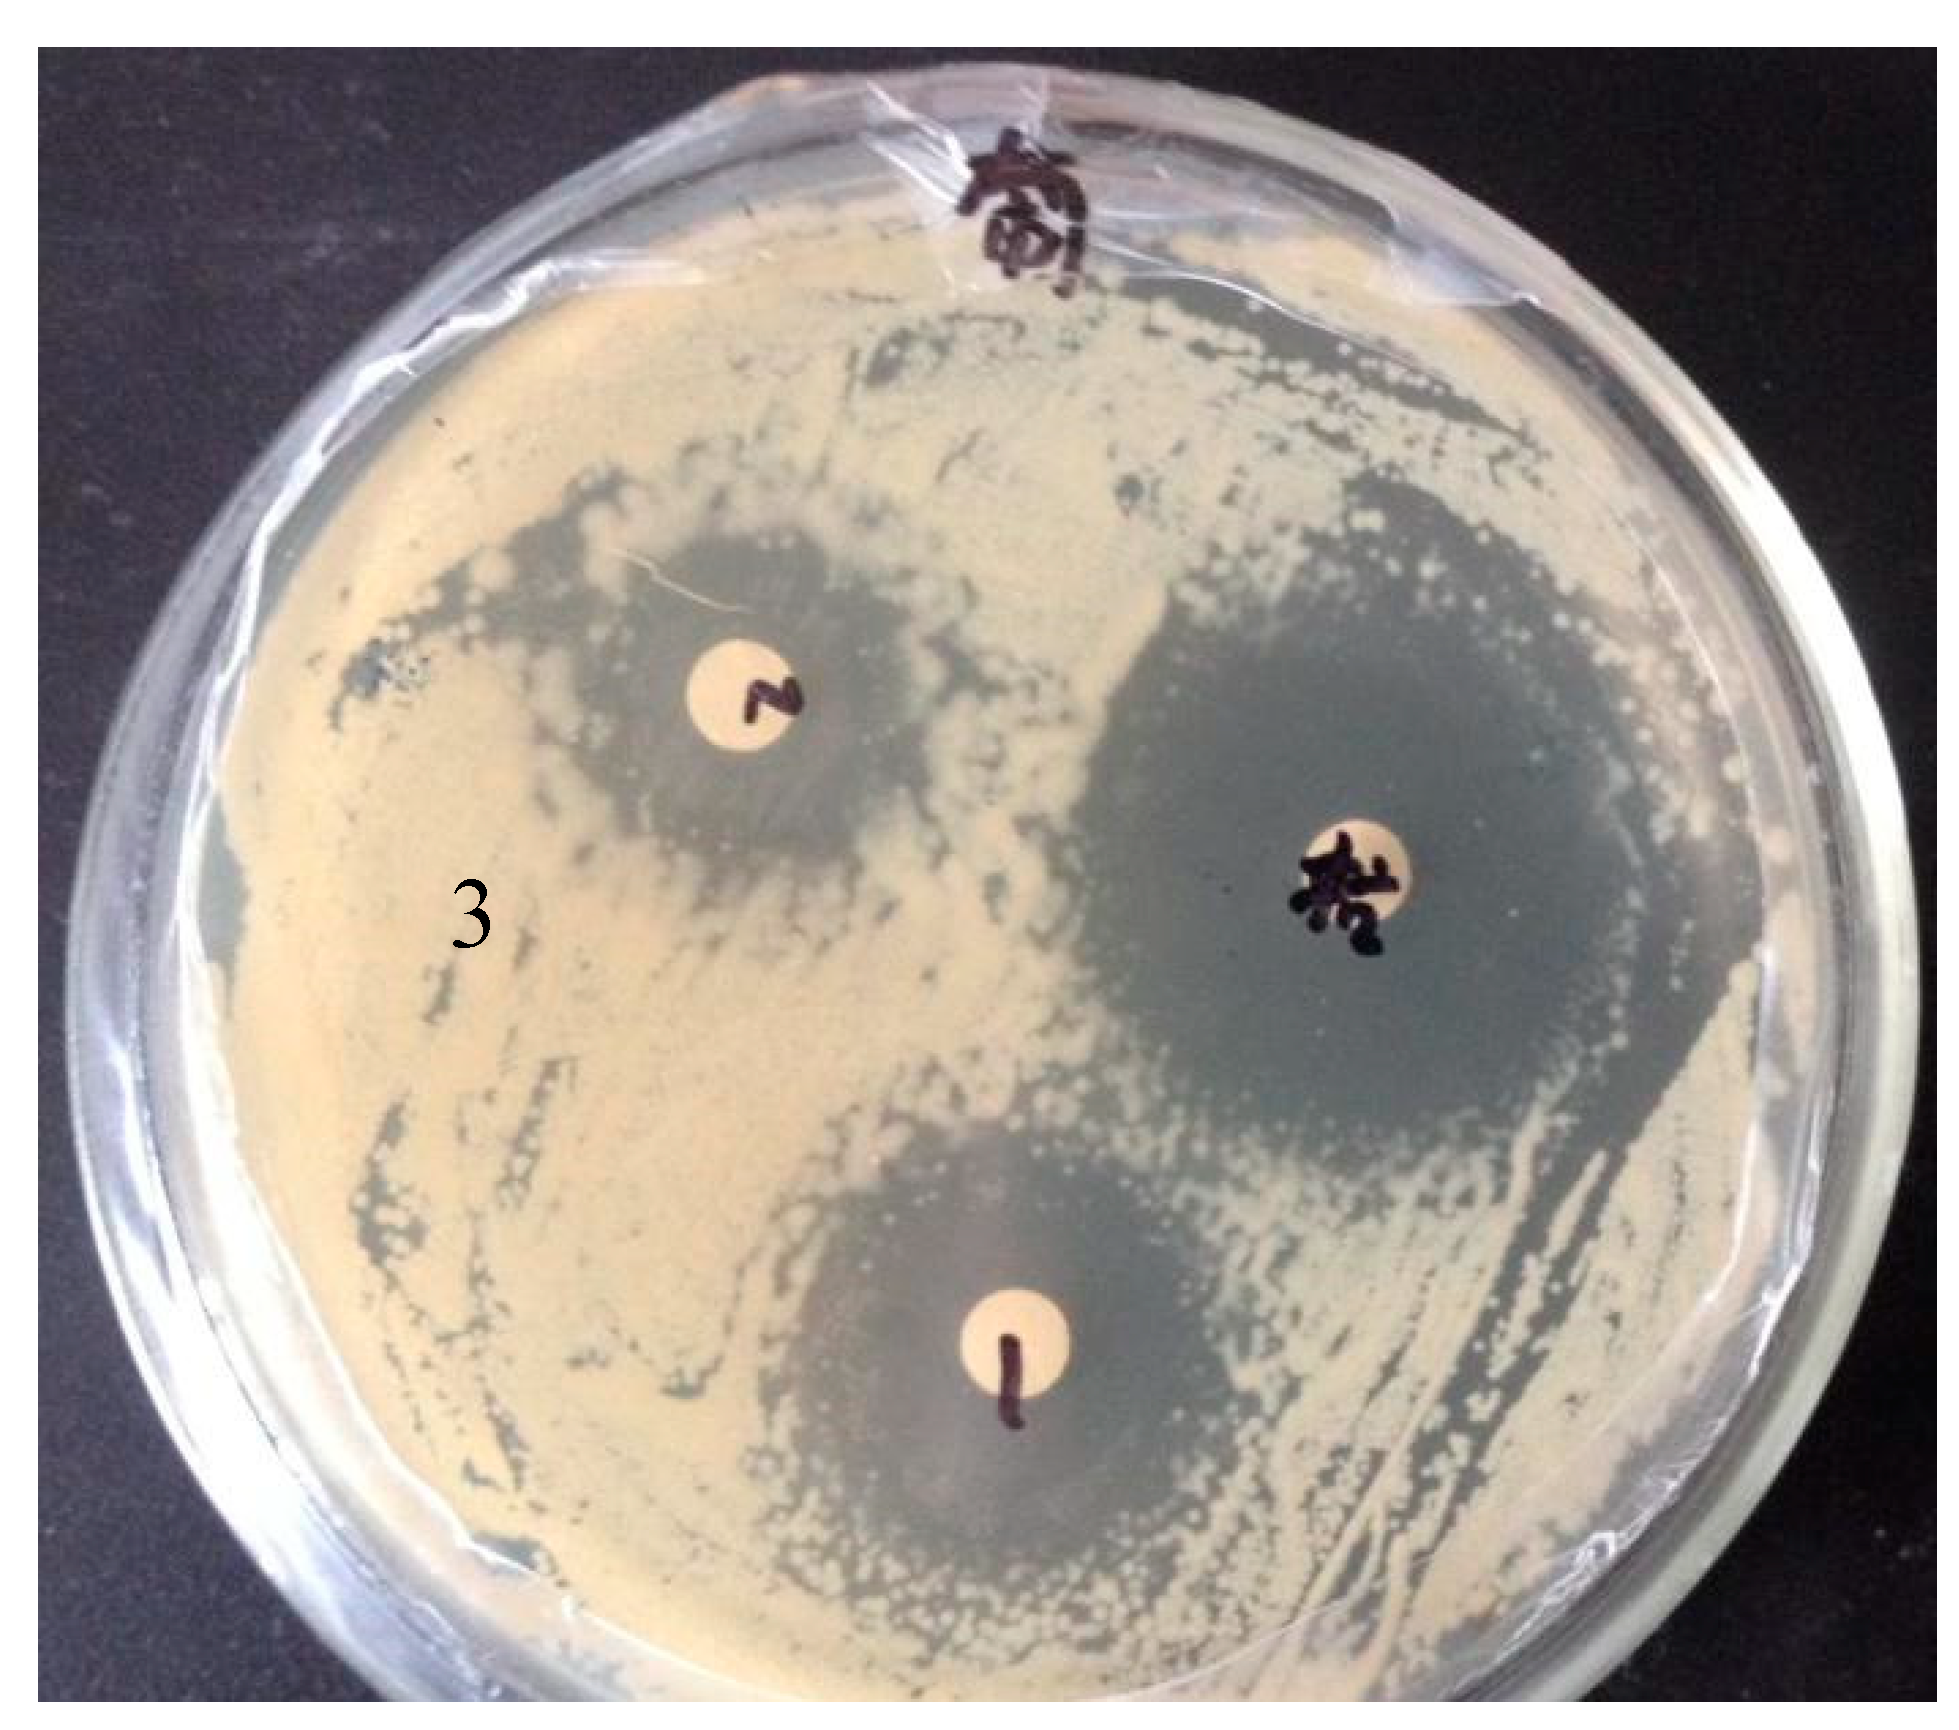
Preprints 90938 g002

1. Introduction
Mastitis, one of the most common infectious diseases in dairy farming, seriously affects milk production and can cause substantial economic losses to the farming industry, and has been a major concern in the livestock farming and food processing industries [
1]. It has been reported that the main pathogenic microorganisms that cause mastitis are bacteria, viruses, mycoplasma, and fungi, and there are more than 150 species, but mainly bacterial pathogens, most of which are caused by
Staphylococcus aureus (S. aureus) and
Escherichia coli (
E. coli.) [2-4]. Various studies have demonstrated that infections caused by Staphylococcus aureus remain the predominant problem in mastitis in dairy cows [
2]. Currently, antibiotics are widely used in the treatment and prevention of mastitis in dairy cows, causing an increase in antibiotic resistance and the production of resistant strains of bacteria, resulting in the use of antibiotic therapy for mastitis being less effective and thus making the treatment of mastitis much more difficult [
5]. Therefore, the search for a new antibacterial agent that is efficient, green, and ecologically sound is urgent.
As a large economic animal, the use of cows as an animal pathology model for research is not only too expensive and difficult to perform but also not suitable for experimental research because of the large individual differences and the inability to standardize laboratory management. The animal model of mastitis in mice is an appropriate simulation of the disease in large animals, etiology, and treatment of diseases and is considered an important method and tool for studying the occurrence and development of diseases and their prevention and control measures [6-8]. In the present day, mice are considered to be the most suitable test animals for studying mammary gland infection and pathogenesis in cows [
9]. Mice have become a pathological model for many studies at home and abroad. Compared to animals such as cows, mice have the advantages of low cost, easy handling, small individual differences, high fertility, easy control of test conditions, and suitable for standardized management, etc. The use of mice as test animals allows for comprehensive bacterial counts, pathological histological changes, and inflammatory cytokines in mastitis in mice are similar to those in dairy cows, which facilitates the study of the pathogenesis and pathogenic mechanisms of mastitis [
10]. In addition, the mouse is a rodent, and although it has significant morphological differences from the mammary gland of ruminants, it is the most typical representative of mammary gland development [
11], making the mouse mastitis pathology model suitable for extensive testing and providing a research base for the development of new drugs to treat mammary gland infections in cows.
Fly maggot antimicrobial peptide is a kind of small molecule peptide with biological activity in the organism; fly maggot antimicrobial peptide, as the body defense peptide, has the effect of anti-bacteria, fungus, viruses, etc., and the antimicrobial peptide acts on the body to produce an antibacterial effect without causing damage to the normal cells of the body, its antibacterial activity is very strong and can inhibit the growth of most bacteria. The larvae and adults of the house fly group live in an environment full of pathogenic microorganisms, including bacteria, fungi, and viruses [
12], and their ability to survive in such a hostile environment is mainly dependent on the unique immune mechanism that exists in the body, especially the antibacterial peptides secreted by the body, which guarantee their normal growth and development [
13].
Based on the above findings, this study was conducted to evaluate the ameliorative effect of myiasis antimicrobial peptides on mastitis in a mouse model. This study aims to address the following questions: (i) evaluate the antimicrobial activity of antimicrobial peptides in vitro models, (ii) design and validate alternative therapies for mastitis without antibiotics, and (iii) evaluate the improvement of antimicrobial peptides in mastitis in terms of clinical symptoms, histopathologic changes, pro-inflammatory factor levels, and staphylococcus aureus counts.
2. Materials and Methods
2.1. Induction and extraction of AMPs from fly maggots
Fly maggots were reared in a natural, artificial climate incubator at 28°C and 65% RH to lay eggs, and 3-day-old fly maggot larvae were collected. An appropriate number of fly maggots were induced by placing them in 30mL of inactivated S.aureus (ATCC, 25923) solution (1×108 CFU/ mL) for one hour and incubated in the artificial climate incubator for 24h. The uninduced group was replaced with an equal volume of sterile water. The maggots were cut up and mixed with the crude extract and then centrifuged and ultrafiltered to obtain the antimicrobial peptide extract. A standard protein curve was prepared, and the concentration of the extract was measured. The AMPs in the extract were separated and purified by gel filtration chromatography and made into a lyophilized powder.
2.2. Determination of antibacterial activity
According to the Kirby-Bauer method (K-B method) recommended by the National Committee for Clinical Laboratory Standardization (2004, NCCLS) standard, the filter paper was punched into 6mm diameter round pieces of paper with a hole punch and autoclaved at 121°C for 30min. The sterilized drug-sensitive paper pieces were immersed in the fly antimicrobial peptide extract, fully immersed, and then transferred to sterile test tubes with sterile forceps and placed in Dried in an oven at 37℃ to make saturated drug-sensitive paper sheets. A concentration of 1×108 CFU/mL of S.aureus 20 μL was inoculated onto LB solid medium, and the drug-sensitive paper sheets were attached to the medium coated with S.aureus. Three replicates of each drug-sensitive paper sheet were incubated at 37℃ for 24 h in a constant temperature incubator, and the diameter (Φ) size of the inhibition circle was measured using vernier calipers.
2.3. Minimum Inhibitory Concentration (MIC) determination
The minimum inhibitory concentrations of AMPs for fly maggots were determined using broth microdilution (M60). Different concentrations of antimicrobial peptide solutions were added to sterile 96-well plates, wells 1-11, with ten μL per well. 100 μL of S.aureus suspension at a concentration equivalent to 0.5 Mackenzie's turbidity standard was added to each well after dilution by MH broth 1:1000. 3.0, 3.5, 4.0, 4.5, and 5.0 mg/L, following the same method with the above concentration of Ciprofloxacin (CPFX) as a control. The 96-well plates were sealed and placed in an incubator at 37°C for 24h, and then observe the bacterial growth. Determination of results: The minimum concentration of antimicrobial peptide that completely inhibits bacterial growth in a small well is the MIC. The test is only meaningful when bacterial growth is evident in the positive control well (i.e., without the antimicrobial drug).
2.4. Establishment of S.aureus mastitis in mice
Thirty female mice at 6-8 d of delivery were randomly divided into six groups (n=5), a blank control group, a saline group, and different doses of S. aureus test group (102 CFU/50 μL, 103 CFU/50 μL, 104 CFU/50 μL, 105 CFU/50 μL), isolated from the litter one h before attacking the bacteria, anesthetized with ether and held in place, 75% alcohol After disinfection, the female mouse nipples were gently picked up with small forceps, and the saline group and each test group were injected with 50 μL of saline or the corresponding bacterial suspension by inserting a microinjector through the mice next to the nipple of the fourth pair of breasts and gently picking the tip of the needle parallel to the top of the mammary gland while retreating, as shown in
Table 1 for the specific test groups and treatments. Twenty-four hours later, mastitis was induced, the mice were executed, and mammary tissue specimens were taken for testing.
After 24 h of bacterial attack, the mice in each group were cervically executed, and the midline of the abdomen was quickly cut open to observe the pathological changes in the mammary glands and surrounding tissues. One side of the mammary gland was fixed in a 10% neutral formaldehyde solution, and paraffin sections were prepared; the other side was aseptically peeled and weighed for bacterial counting and Tumor necrosis factor-α (TNF-α) detection.
The clinical symptoms, the appearance of the mammary region, the number of S.aureus in mammary tissue, pathological changes of mammary tissue, and changes in cytokine levels were observed to determine whether mastitis was caused. Breast swelling, red breast tissue color, bleeding phenomenon, the number of bacteria in breast tissue more than 102CFU/g, and obvious pathological changes in breast tissue were judged as lesions. According to the number of bacteria per gram of breast tissue, the degree of breast infection was divided into severe infection (>108 CFU), moderate infection (105~108CFU), mildly infected (102~105CFU), and uninfected (<102CFU) [
14].
2.5. Treatment
One hundred and twenty female rats at 6-8 d postnatal were randomly divided into four experimental groups (blank control group, saline-treated group, fly maggot antibacterial peptide treated group, and antibiotic-treated group), with 30 rats in each group. 3 The other three groups of female mice were anesthetized with ether and then disinfected with 75% alcohol on the fourth pair of teats. The female teats were then gently picked up with small forceps, inserted with a microinjector next to the teats of the fourth pair of mice, and the tip of the needle was gently picked parallel to the top of the mammary gland and injected while retreating. All mice showed signs of depression and reduced diet 24 hours after injection.
Clinical criteria for the development of mastitis: check the degree of swelling of the udder, the mental state of the mice, the condition of the coat, and the change of activity 24h after attacking the bacteria; if the mice show depression, reduced activity, and disheveled coat, it is judged as the development of disease, if the above symptoms are not obvious, it is judged as not developed.
Clinical criteria for the cure of mastitis: after 7 d of treatment, mice returned to normal mental status, diet, and water intake, and the number of S.aureus in mammary tissue was <102 /g.
After the successful establishment of the mouse mastitis pathological model, each group of mice was fed with the appropriate drug, and the specific dosing regimen is shown in
Table 2.
3. Results
This section may be divided by subheadings. It should provide a concise and precise description of the experimental results, their interpretation, as well as the experimental conclusions that can be drawn.
3.1. Concentration of crude extract of antibacterial peptide from fly maggots
3.1.1. Bovine serum protein standard curve
The OD595 value of bovine serum standard protein was measured using a spectrophotometer, and the standard curve was plotted using the concentration of bovine serum standard protein (mg/mL) as the horizontal coordinate and the absorbance value OD595 as the vertical coordinate to obtain the standard curve equation, y = 0.5834x + 0.056, R2 = 0.9782, as shown in
Figure 1.
3.1.2. Results of the determination of the concentration of AMPs in fly maggots
The OD value of the antimicrobial peptide in fly maggots was determined by using the Kormas Brilliant Blue method, and the concentration of the antimicrobial peptide in fly maggots was calculated according to the standard curve of protein concentration determination in
Figure 1 (
Table 3), the concentration of the antimicrobial peptide in fly maggots was 22.23 μg/ml in the uninduced group and 25.36 μg/ml in the induced group by S. aureus. The concentration of antimicrobial peptide in the S. aureus-induced group was significantly higher than that in the non-induced group (p<0.05).
3.2. Results of the antibacterial activity of the antimicrobial peptide for fly maggots
The results of the K-B paper diffusion method to determine the antibacterial activity of the antibacterial peptides of fly maggots (
Table 4,
Figure 2) showed that the antibacterial peptides of fly maggots induced by S. aureus, the antibacterial peptides of fly maggots not induced by S. aureus and the antibiotic (CPFX) all had an inhibitory effect on S. aureus, and the diameter of the inhibition circle of the antibacterial peptides of fly maggots induced by S. aureus and the antibiotic (CPFX) was significantly The inhibition circle diameter of the antibiotic group was significantly larger than that of the non-induced peptide (p<0.05), and the inhibition circle diameter of the antibiotic group was significantly larger than that of the S. aureus-induced group (p<0.05), suggesting that the inhibition activity of the induced peptide against S. aureus was significantly larger than that of the non-induced peptide.
3.3. Results of the minimum inhibitory concentration of AMPs for fly maggots
The results of the minimum inhibitory concentrations of antibacterial peptides for fly maggots (Tables 5) showed that the minimum inhibitory concentration for S.aureus was 1.5 mg/L for fly maggots and one mg/L for CPFX.
3.4. Establishment of an S.aureus mastitis model in mice
3.4.1. Observation of clinical symptoms of mastitis in mice
After attacking the bacteria, the female rats in the blank control and saline groups were in a normal mental state; the female rats in the 102 CFU/50 μL treatment group had reduced water intake and food intake; the female rats in the 103 CFU/50 μL and 104 CFU/50 μL treatment groups were depressed, reduced water intake and food intake, disheveled coat, large amount of discharge from the corner of the eyes, unresponsive, curled up, and red and swollen mammary area.
3.4.2. Observations of histopathological changes in the breast
After dissection, the results of histopathological changes in the mammary glands of mice observed by visual inspection (
Figure 3) showed that the mammary glands of mice in the blank control and saline groups were milky white with no pathological changes; the mammary glands of mice in the 102 CFU /50 μL treatment group were mildly congested; the 103 CFU /50 μL treatment group showed typical pathological changes such as redness, swelling and congestion; the 104 CFU /50 μL treatment group and the 105 CFU /50 μL-treated group showed adhesion of breast tissue to the peritoneum, atrophy and erosion.
3.4.3. Histological Observation of mammary gland pathology in mice
The results of Hematoxylin and eosin (HE) -stained histological sections of mammary gland tissues of mice (
Figure 4) showed that there were no pathological changes in the blank control group and saline group, and the mammary gland follicles were normally developed, evenly distributed, and the mammary epithelial cells were intact and neatly arranged (
Figure 4A and B); the mammary gland tissues of the 102 CFU/50 μL-treated group were structurally intact, and lymphocytes were occasionally seen (
Figure 4C); the mammary gland tissues of the 103 CFU/50 μl-treated group had complete breast tissue structure, with some lymphocytes and erythrocytes infiltrated, and the wall of the breast follicle was obviously hyperplastic, with epithelial cells shed and the wall of the follicle partially intact (
Figure 4D); 104 CFU/50μL-treated group and 105 CFU/50μL-treated group had uneven distribution of breast follicles, with a large number of epithelial cells shed in clusters, a large number of erythrocytes infiltrated in the tissue interstices, and the breast structure collapsed and blurred. A large number of inflammatory cells infiltrated the interstitial space, and the glandular follicles were disintegrated and necrotic (
Figure 4E, F).
3.4.4. Results of S.aureus count in breast tissue
The number of Staphylococcus aureus in the mammary tissue of mice was detected by plate counting method, and a single colony in the plate was selected for Gram staining. The results in
Figure 5 proved that the bacteria infected with the mice was Staphylococcus aureus. The results in
Table 6 show that no bacteria were detected in the mammary glands of the blank control group and saline group, and the incidence of mastitis in the mammary glands of the mice was 0; only a small number of mice in the 102 CFU/50μL treated group developed mastitis and the mortality rate was 0; the incidence of mastitis in the 10 CFU/50μL treated group and the 10 CFU/50μL treated group was 100% and no mice died; the incidence of mastitis in the 10 CFU/50μL treated group and the 10 CFU/50μL treated group was 100% and no mice died. The incidence of mastitis was 100% in the 103 CFU/50μL treated group, and no mice died; the incidence of mastitis was 100% in the 104 CFU/50μL treated group, and the mortality rate was 60% and 100% in the 105 CFU/50μL treated group, respectively.
3.4.5. Results of the TNF-α assay in breast tissue
The results of TNF-α in the mammary tissues of mice in each test group were measured by ELISA kit (e Bioscience) (
Table 7). The difference in TNF-α in the mammary tissues of mice in the saline group compared with the blank control group was not significant (p>0.05); the TNF-α in the mammary tissues of mice in the 102 CFU/50μL treated group, 103 CFU/50μL treated group, 104 CFU/50μL treated group, and 10 CFU/50μL treated group were all very significantly higher than that in the saline group (p<0.01). /50 μL treated group, 105 CFU/50 μL treated group, 10 CFU/50 μL treated group, TNF-α in mammary tissue of mice were all extremely significantly higher than those in the saline group (p<0.01).
3.5. Clinical treatment trials
3.5.1. Observation of clinical symptoms in mice
During the treatment, the mice in the blank control group were in good spirits, while the mice in the saline-treated group were depressed, had a lot of yellow discharge from the corners of their eyes, their coats were disheveled, their appetite and water intake slowly decreased and were deprived of appetite on the fourth day of treatment. The mice in the antibacterial peptide and antibiotic (CPFX) treatment groups gradually recovered. Mice treated with antimicrobial peptides had significantly reduced symptoms of breast redness and swelling and decreased breast weight.
3.5.2. Histological Observation of mammary gland pathology in mice Results
After treatment, mammary gland tissues were collected from each test group, and pathological tissue sections were prepared using HE staining. Representative histological sections were selected to observe the pathological changes in the mammary tissues of mice in each experimental group, and the observed results are shown in
Figure 6. A1, A2 and A3 were the pathological sections of the mammary tissue of the blank control group on the 3rd, 5th and 7th day. The mammary tissue structure was intact, the mammary epithelial cells were complete and arranged neatly, and there was no inflammatory cell infiltration and pathological changes; B1 and B2 are histopathological sections of the mammary glands of mice treated with saline, with uneven distribution of mammary vesicles, rupture of the vesicle wall, large number of erythrocytes, and inflammatory cells in the interstitial space, the collapse of the mammary gland structure, blurring of the mammary gland, disintegration and necrosis of the vesicles; C1, C2 and C3 are histopathological sections of the mammary glands of mice treated with fly maggot antibacterial peptide for 3, 5 and 7 days, respectively; C1 is a histopathological section of the mammary glands of mice treated with fly maggot antibacterial peptide for 3, 5 and 7 days. C2 mammary tissue is structurally broken with inflammatory and erythrocyte infiltration; C3 mammary tissue is structurally intact with a small amount of inflammatory and erythrocyte infiltration; D1, D2, and D3 are histopathological sections of mammary tissue from mice treated with antibiotics (CPFX) for 3, 5 and 7 d, respectively; D1 mammary tissue is structurally intact with inflammatory and erythrocyte infiltration D2 and D are histopathological sections of the mammary glands of mice treated with antibiotics (CPFX) for 3, 5 and 7 d respectively.
3.5.3. Results of TNF-α in breast tissue
The results of the detection of TNF-α content in the mammary tissues of mice in each test group showed (
Table 8,
Figure 7) that the TNF-α content in the mammary tissues of mice in the antibacterial peptide treatment group and the antibiotic treatment group showed a decreasing trend during the treatment, and the TNF-α content in the mammary tissues of mice was highly significantly down-regulated compared with the saline treatment group (P < 0.01), but after the end of the treatment, the antibacterial peptide However, the TNF-α content in the mammary tissues of mice in the antimicrobial peptide treated group and the antimicrobial agent treated group was still significantly higher than that in the blank control group (P < 0.05), indicating that the antimicrobial peptide of fly maggot had a certain inhibitory effect on TNF-α.
3.6. Results of S.aureus count in breast tissue
During the treatment of S.aureus mastitis in mice with the antibacterial peptide of fly maggot, the plate count method was used to detect the number of S. aureus in the mammary tissues of mice in each test group, and individual colonies in the plates were picked for Gram staining. The results in
Figure 8 proved that the mastitis in mice was caused by S. aureus. The results in
Table 9 showed that during the treatment process, the number of S. aureus in the mammary tissues of mice in the saline-treated group. The number of S.aureus in the mammary tissues of mice in the saline-treated group showed an increasing trend, while the number of S.aureus in the mammary tissues of mice in the antibacterial peptide-treated group and the antibiotic-treated group showed a decreasing trend, and the number of S.aureus in the mammary tissues of mice in the third and fifth day of treatment was significantly lower than that of the saline-treated group (p < 0.01). The cure rate of S.aureus mastitis in mice was 0 in the saline group, 40% in the antibacterial peptide group, and 80% in the antibiotic group.
4. Discussion
The antimicrobial spectrum of Staphylococcus aureus (S. aureus) was determined by the K-B method, and the minimum inhibitory concentration (MIC) was determined by the broth microdi-lution (M60) to evaluate the inhibitory activity of the antimicrobial peptides. It was found that both the antimicrobial peptide produced by S. aureus-induced fly maggots and the antimicrobial peptide produced by uninduced fly maggots were able to inhibit the growth of S. aureus, but the diameter of the circle of inhibition of the antimicrobial peptide produced by S. aureus-induced fly maggots (19.97±0.65) was significantly larger than the diameter of the circle of inhibition of the antimicrobial peptide produced by uninduced fly maggots (13.82±0.79) (p<0.05). (13.82±0.79) (P<0.05), in agreement with the results of [
15]. The broth dilution method was used to determine the minimum inhibitory concentration of S. aureus-induced fly maggot disease AMPs against S. aureus. The results showed that the MIC of fly maggot AMPs against Staphylococcus aureus was 1.5 mg/L, and the MIC of Ciprofloxacin against Staphylococcus aureus was 1 mg/L. Fly maggot antimicrobial peptides exhibited strong inhibition against Escherichia coli, Salmonella typhimurium, Staphylococcus aureus, and Helicobacter pylori [16-18].
Mice belong to rodents; although there are significant morphological differences with the mammary glands of ruminants, their mammary gland structure is similar to that of lactating animals [
11], and they have become the animal of choice for the establishment of a pathological model of mastitis, which will provide a research basis for the development of new drugs for the treatment of mammary gland infections in dairy cows. In this study, a microfeeder [
19] was used to inject the bacterial suspension into the mammary tissue by puncturing from the side of the teat, which caused less damage to the mammary tissue due to the smaller injection needle, and there was basically no visible pathological changes in the saline group compared with the blank control group, thus indicating that the use of teat skin injection had no effect on this test. The incidence rate of mouse mastitis in the 102CFU/50uL treatment group was 33.33%, which was low and unsuitable for bacterial attacking dosage; the incidence rate of mouse mastitis in the 104CFU/50uL and 105CFU/50uL treatment groups was 100%; however, the damage to mouse mammary gland tissues was serious, and the structure of mammary gland tissues was completely collapsed, which caused death of the mice and was not suitable for cooperation with mouse mastitis model; the pathological and histological observations in the 103CFU/50uL treatment group showed typical redness, swelling, congestion and other pathological changes in mouse mammary tissues with complete structure. However, in the 103CFU/50uL treatment group, the mammary tissue of mice showed typical pathological changes such as redness, swelling, and congestion, and the pathological histological observations showed that the mammary tissue of mice was structurally intact, with inflammatory cells and erythrocyte infiltration, and the incidence rate of mastitis was 100%, and there were no deaths of mice, which made it more suitable for the establishment of the optimal pathological model of Staphylococcus aureus mastitis in mice.
After the mice were successfully infected with mastitis, the antimicrobial peptide of fly maggots played a positive role in improving the symptoms during the treatment process. After being treated with the antimicrobial peptide, the mammary glands of mice showed a significant decrease in erythema symptoms and a decrease in mammary gland weight, which is consistent with the results of [20-21]. Therefore, from the present study, it can be hypothesized that fly maggot antimicrobial peptide plays a similar effect to ciprofloxacin antibiotic to improve the symptoms of mastitis in mice, as evidenced by the significant increase in the mental status, diet, and water intake of the mice.
According to the report, S. aureus infection resulted in significant pathological damage, the normal structure of mammary glands disappeared, the purulent foci were evident, and significant inflammatory cells were infiltrated in mammary glands [
21]. It has been reported that mammary gland weight decreases in mice with Staphylococcus aureus infection [
14]. Studies have shown that after infection with S. aureus induced mastitis, mice are weak, lose body weight, and have reduced food intake and water intake [
22]. In the blank control group, the distribution of mammary acins was uneven; the acinar wall was ruptured, there were a large number of red blood cells and inflammatory cells infiltrated in the interstitial space, the mammary structure collapsed, blurred, and the acins were disintegrated and necrotic. In the course of 3, 5, and 7 days of treatment, the mental state, diet, and water intake of the mice in the antimicrobial peptide treatment group and the antibiotic treatment group gradually recovered, and the inflammatory cells and red blood cell infiltration in the mammary tissue of the mice were gradually reduced. In addition, TNF-α is an endogenous mediator that regulates inflammation or is related to inflammatory response. It is usually synthesized and released by stimulated lymphocytes, monocytes, macrophages, and endothelial cells in the early stage of inflammation. It plays a key role in the inflammatory response of the body and is considered the main cytokine of inflammatory response [23-24]. TNF-α has dual biological effects. At a low concentration, Tnf-α is involved in resisting bacterial, viral, and parasitic infections, promoting tissue repair, regulating inflammatory responses, and causing tumor cell apoptosis. At high concentrations, excessive production and release of TNF-α in the body will destroy the immune balance of the body and have biological toxic effects on many cells, which can induce both cell necrosis and apoptosis [25-27]. In our results, TNF-α was significantly elevated in the antibiotic group compared with the saline and blank control groups. In infected breast tissue, several studies have also reported elevated TNF-α [28-31].
The number of S. aureus in mouse mammary tissues can reflect the infectious bacteria in mammary tissues. In this experiment, we detected the number of S. aureus in mouse mammary tissues using mannitol salt agar and found that fly antimicrobial peptide could reduce the number of S. aureus in mouse mammary tissues extremely significantly (p<0.01) in comparison with that in the saline group. A study reported that topical application of antimicrobial peptides for fly maggots was effective in reducing the survival rate of S. aureus and promoting wound healing [
18]. Antimicrobial peptides were also reported to be effective in inhibiting S. aureus by [
32].
5. Conclusions
In summary, the current study supports the therapeutic effect of the antimicrobial peptide of fly maggots on mastitis caused by S. aureus in mice. This provides a preliminary proof of concept for the use of fly AMPs as antimicrobial agents in the treatment of bovine mastitis caused by S. aureus. More in vivo trials, including a longer cycle from clinical diagnosis to dosing, are needed to assess the true merits of this approach.
Supplementary Materials
The data of this manuscript have been submitted to the journal's official website.
Author Contributions
For research articles with several authors, a short paragraph specifying their individual contributions must be provided. The following statements should be used “Conceptualization, S.H. and W.J.; methodology, W.Z.; software, C.S.; validation, G.M.; formal analysis, M.Y.; investigation, Z.H.; resources, S.H.; data curation, W.Z.; writing—original draft preparation, W.Z.; writing—review and editing, W.Z.; supervision, G.S.; project administration, W.J.; funding acquisition, S.H. All authors have read and agreed to the published version of the manuscript.”.
Funding
Funding support: all funding came from the Chinese teacher program "Tianshan Talents" Education and Teaching Master Program, project No. CZ004303.
Institutional Review Board Statement
The study was approved by the Animal Experimentation Ethics Committee of the School of Animal Science and Technology, Shihezi University. The code of ethical inspection was A2021-14. All chickens were kept experimentally and euthanized per the committee’s guidelines. During the test, all efforts were made to minimize the suffering of the animals.
Informed Consent Statement
The study was approved by the Ethics Committee for Animal Experiments of the College of Animal Science and Technology, Shihezi University. All chickens were experimented and euthanized in strict accordance with the guidelines of the committee. Every effort was made to minimize the suffering of the animals during the experiment.
Data Availability Statement
All the data generated from this research are available upon reasonable.
Acknowledgments
Authors are thankful to Professor Shen Hong and Professor Wang Jungang for their financial support, Professor Nie Cunxi and Professor Zhang Wenju for their assisted research, and the School of Animal Science and Technology, Shihezi University for their research facilities and care of the experimental animals.
Conflicts of Interest
All the authors declare no conflicts of interest.
References
- Bradley, A. J. , Bovine Mastitis: An Evolving Disease. The Veterinary Journal 2002, 164, 116–128. [Google Scholar] [CrossRef] [PubMed]
- Cobirka, M.; Tancin, V.; Slama, P. , Epidemiology and Classification of Mastitis. Animals 2020, 10, 2212. [Google Scholar] [CrossRef] [PubMed]
- Heikkilä, A. M.; Liski, E.; Pyörälä, S.; Taponen, S. , Pathogen-specific production losses in bovine mastitis. J Dairy Sci 2018, 101, 9493–9504. [Google Scholar] [CrossRef] [PubMed]
- Keshavarz, M.; Barati-Boldaji, R.; Mazloomi, S. M.; Yousefi, M. H. , Effect of inoculation of Lactobacillus acidophilus on the level of nitrite and nitrate in yogurt containing spinach during refrigeration in 21 days. Functional Foods in Health and Disease 2022, 12, 188–197. [Google Scholar] [CrossRef]
- Cheng, W. N.; Han, S. G. , Bovine mastitis: risk factors, therapeutic strategies, and alternative treatments — A review. Asian-Australas J Anim Sci, 2020; 33, 1699–1713. [Google Scholar] [CrossRef]
- Soni, S.; Mukherjee, R.; De, U. K.; Bharti, D.; Singh, M.; Bhagirathi, B. R. P.; Gandhar, J. S.; Sarkar, V. K.; Kumar, A.; Raghuvaran, R. , Preparation and characterization of chitosan encapsulated beta-lactam antibiotic and baicalein nanoparticles. The Pharma Innovation Journal 2022, 11, 2198–2201. [Google Scholar]
- Suresh, S.; Sankar, P.; Kalaivanan, R.; Telang, A. G. , Ameliorative effect of nanocurcumin on Staphylococcus aureus-induced mouse mastitis by oxidative stress suppression. Inorganic and Nano-Metal Chemistry, 2022; 52, 1003–1011. [Google Scholar] [CrossRef]
- Vasileiou, N.; Cripps, P.; Ioannidi, K.; Katsafadou, A.; Chatzopoulos, D.; Barbagianni, M.; Tsioli, V.; Dermisiadou, E.; Karavanis, E.; Papadopoulos, N. , Experimental study for evaluation of the efficacy of a biofilm-embedded bacteria-based vaccine against Staphylococcus chromogenes-associated mastitis in sheep. Veterinary microbiology 2019, 239, 108480. [Google Scholar] [CrossRef] [PubMed]
- Ingman, W. V.; Glynn, D. J.; Hutchinson, M. R. , Mouse models of mastitis – how physiological are they? International Breastfeeding Journal 2015, 10, 12. [Google Scholar] [CrossRef] [PubMed]
- Brouillette, E.; Malouin, F. , The pathogenesis and control of Staphylococcus aureus-induced mastitis: study models in the mouse. Microbes and Infection 2005, 7, 560–568. [Google Scholar] [CrossRef] [PubMed]
- Richert, M. M.; Schwertfeger, K. L.; Ryder, J. W.; Anderson, S. M. , An atlas of mouse mammary gland development. Journal of mammary gland biology and neoplasia 2000, 5, 227–241. [Google Scholar] [CrossRef]
- Yin, J.-H.; Kelly, P. J.; Wang, C. , Flies as Vectors and Potential Sentinels for Bacterial Pathogens and Antimicrobial Resistance: A Review. Veterinary Sciences 2022, 9, 300. [Google Scholar] [CrossRef]
- Rahuma, N.; Ghenghesh, K.; Ben Aissa, R.; Elamaari, A. , Carriage by the housefly (Musca domestica) of multiple-antibiotic-resistant bacteria that are potentially pathogenic to humans, in hospital and other urban environments in Misurata, Libya. Annals of Tropical Medicine & Parasitology, 2005; 99, 795–802. [Google Scholar] [CrossRef]
- Chinchali, J. F.; Kaliwal, B. , Histopathology of mammary gland in Staphylococcus aureus induced mastitis in mice. Asian Pacific Journal of Tropical Disease 2014, 4. [Google Scholar] [CrossRef]
- Zhang, J.; Li, J.; Peng, Y.; Gao, X.; Song, Q.; Zhang, H.; Elhag, O.; Cai, M.; Zheng, L.; Yu, Z.; Zhang, J. , Structural and functional characterizations and heterogenous expression of the antimicrobial peptides, Hidefensins, from black soldier fly, Hermetia illucens (L.). Protein Expression and Purification, 2022; 192, 106032. [Google Scholar] [CrossRef]
- Peng, J.; Wu, Z.; Liu, W.; Long, H.; Zhu, G.; Guo, G.; Wu, J. , Antimicrobial functional divergence of the cecropin antibacterial peptide gene family in Musca domestica. Parasites & vectors, 2019; 12, 1–10. [Google Scholar] [CrossRef]
- Wu, S.; Wang, J.; Zhu, L.; Ren, H.; Yang, X. , A novel apidaecin Api-PR19 synergizes with the gut microbial community to maintain intestinal health and promote growth performance of broilers. Journal of Animal Science and Biotechnology 2020, 11, 1–18. [Google Scholar] [CrossRef] [PubMed]
- Zhang, Z.; Wang, J.; Zhang, B.; Liu, H.; Song, W.; He, J.; Lv, D.; Wang, S.; Xu, X. , Activity of antibacterial protein from maggots against Staphylococcus aureus in vitro and in vivo. Int J Mol Med 2013, 31, 1159–1165. [Google Scholar] [CrossRef]
- Lee, J.-W.; Paape, M.; Zhao, X. , Recombinant bovine soluble CD14 reduces severity of experimental Escherichia coli mastitis in mice. Veterinary Research 2003, 34, 307–316. [Google Scholar] [CrossRef] [PubMed]
- Geng, N.; Gao, X.; Wang, X.; Cui, S.; Wang, J.; Liu, Y.; Chen, W.; Liu, J. , Hydrogen helps to ameliorate Staphylococcus aureus-induced mastitis in mice. International Immunopharmacology 2022, 109, 108940. [Google Scholar] [CrossRef] [PubMed]
- Taifa, S.; Muhee, A.; Bhat, R. A.; Nabi, S. U.; Roy, A.; Rather, G. A.; Khan, A. A.; Bashir, S. M.; Patwekar, M.; Wahab, S. , Evaluation of therapeutic efficacy of copper nanoparticles in Staphylococcus aureus-induced rat mastitis model. Journal of Nanomaterials 2022, 2022. [Google Scholar] [CrossRef]
- Notebaert, S.; Demon, D.; Berghe, T. V.; Vandenabeele, P.; Meyer, E. , Inflammatory mediators in Escherichia coli-induced mastitis in mice. Comparative immunology, microbiology and infectious diseases, 2008; 31, 551–565. [Google Scholar] [CrossRef]
- Alluwaimi, A. M.; Leutenegger, C. M.; Farver, T. B.; Rossitto, P. V.; Smith, W. L.; Cullor, J. S. , The Cytokine Markers in Staphylococcus aureus Mastitis of Bovine Mammary Gland. Journal of Veterinary Medicine, Series B, 2003; 50, 105–111. [Google Scholar] [CrossRef]
- Zelová, H.; Hošek, J. , TNF-α signalling and inflammation: interactions between old acquaintances. Inflammation Research 2013, 62, 641–651. [Google Scholar] [CrossRef] [PubMed]
- Balkwill, F. , Tumor necrosis factor or tumor promoting factor? Cytokine & Growth Factor Reviews, 2002; 13, 135–141. [Google Scholar] [CrossRef]
- Chu, W.-M. , Tumor necrosis factor. Cancer Letters 2013, 328, 222–225. [Google Scholar] [CrossRef]
- Vincenzi, A.; Goettert, M. I.; de Souza, C. F. V. , An evaluation of the effects of probiotics on tumoral necrosis factor (TNF-α) signaling and gene expression. Cytokine & Growth Factor Reviews, 2021; 57, 27–38. [Google Scholar] [CrossRef]
- Akhtar, M.; Shaukat, A.; Zahoor, A.; Chen, Y.; Wang, Y.; Yang, M.; Umar, T.; Guo, M.; Deng, G. , Hederacoside-C Inhibition of Staphylococcus aureus-Induced Mastitis via TLR2 & TLR4 and Their Downstream Signaling NF-κB and MAPKs Pathways In Vivo and In Vitro. Inflammation 2020, 43, 579–594. [Google Scholar] [CrossRef]
- Guo, W.; Liu, B.; Hu, G.; Kan, X.; Li, Y.; Gong, Q.; Xu, D.; Ma, H.; Cao, Y.; Huang, B.; Fu, S.; Liu, J. , Vanillin protects the blood–milk barrier and inhibits the inflammatory response in LPS-induced mastitis in mice. Toxicology and Applied Pharmacology 2019, 365, 9–18. [Google Scholar] [CrossRef]
- Ibrahim, H. , Cytokine Response and Oxidative Stress Status in Dairy Cows with Acute Clinical Mastitis. Journal of Dairy, Veterinary & Animal Research, 2015; 3. [Google Scholar] [CrossRef]
- Li, M.-Y.; Sun, L.; Niu, X.-T.; Chen, X.-M.; Tian, J.-X.; Kong, Y.-D.; Wang, G.-Q. , Astaxanthin protects lipopolysaccharide-induced inflammatory response in Channa argus through inhibiting NF-κB and MAPKs signaling pathways. Fish & Shellfish Immunology, 2019; 86, 280–286. [Google Scholar] [CrossRef]
- Arora, S.; Baptista, C.; Lim, C. S. , Maggot metabolites and their combinatory effects with antibiotic on Staphylococcus aureus. Annals of Clinical Microbiology and Antimicrobials 2011, 10, 6. [Google Scholar] [CrossRef] [PubMed]
Figure 1.
Standard curve of protein concentration.
Figure 1.
Standard curve of protein concentration.
Figure 2.
Diameter of inhibition zone at different groups. Note: CPFX = Ciprofloxacin. 1 S.aureus induced group; 2 uninduced group; 3 antibiotic (CPFX) group.
Figure 2.
Diameter of inhibition zone at different groups. Note: CPFX = Ciprofloxacin. 1 S.aureus induced group; 2 uninduced group; 3 antibiotic (CPFX) group.
Figure 3.
Pathological changes of breast tissue in mice. Note: A is the blank control group; B is the saline group; C is the 102 cfu /50 μ L treatment group; D is the 103 cfu /50 μL treatment group; E is the 104 cfu /50 μL treatment group; F is the 105 cfu /50 μL treatment group. A is the control group; B is the physiological saline group; C is the 102 cfu /50 μL treatment group; D is the 103 cfu /50 μL treatment group; E is the 104 cfu /50 μL group; F is the 105 cfu /50 μL group.
Figure 3.
Pathological changes of breast tissue in mice. Note: A is the blank control group; B is the saline group; C is the 102 cfu /50 μ L treatment group; D is the 103 cfu /50 μL treatment group; E is the 104 cfu /50 μL treatment group; F is the 105 cfu /50 μL treatment group. A is the control group; B is the physiological saline group; C is the 102 cfu /50 μL treatment group; D is the 103 cfu /50 μL treatment group; E is the 104 cfu /50 μL group; F is the 105 cfu /50 μL group.
Figure 4.
histopathological changes in the breast (40×, Hematoxylin and eosin). Note: A is the blank control group; B is the saline group; C is the 102 CFU /50μL treatment group; D is the 103 CFU /50μL treatment group; E is the 104 CFU /50μL group; F is the 105 CFU /50μL group.
Figure 4.
histopathological changes in the breast (40×, Hematoxylin and eosin). Note: A is the blank control group; B is the saline group; C is the 102 CFU /50μL treatment group; D is the 103 CFU /50μL treatment group; E is the 104 CFU /50μL group; F is the 105 CFU /50μL group.
Figure 5.
Gram stain results.
Figure 5.
Gram stain results.
Figure 6.
Pathological changes in breast tissue. Note: A1, A2, and A3 were images of breast tissue pathological changes of 3, 5, and 7d respectively. B1 and B2 are the pathological changes of breast tissue of 3, 5 d of the physiological saline group. C11, C2, and C3 were the pathological changes of breast tissue of 3, 5, and 7d in the treatment group of AMPs. 2 and D3 were the pathological changes of breast tissue of 3, 5, and 7d in the antibiotic treatment group.
Figure 6.
Pathological changes in breast tissue. Note: A1, A2, and A3 were images of breast tissue pathological changes of 3, 5, and 7d respectively. B1 and B2 are the pathological changes of breast tissue of 3, 5 d of the physiological saline group. C11, C2, and C3 were the pathological changes of breast tissue of 3, 5, and 7d in the treatment group of AMPs. 2 and D3 were the pathological changes of breast tissue of 3, 5, and 7d in the antibiotic treatment group.
Figure 7.
Breast tissue TNF-α content.
Figure 7.
Breast tissue TNF-α content.
Figure 8.
Gram stain results.
Figure 8.
Gram stain results.
Table 1.
Experimental group and treatment.
Table 1.
Experimental group and treatment.
| Experimental groups |
Experimental treatment |
| Blank control group |
Left untreated and executed after 24 h |
| Physiological saline group |
The fourth mammary gland pair was injected with 50 uL of saline and killed 24 hours after attacking the bacteria. |
| 102 CFU/50 μL treatment group |
The fourth mammary gland pair was injected with 50 μL of a bacterial suspension of 102 CFU/50 μL and killed 24 h after attacking the bacteria. |
| 103 CFU/50 μL treatment group |
The fourth mammary gland pair was injected with 50 μL of a bacterial suspension of 103 CFU/50 μL and killed 24 h after attacking the bacteria. |
| 104 CFU/50 μL treatment group |
The fourth mammary gland pair was injected with 50 μL of a bacterial suspension of 104 CFU/50 μL and killed after 24 h of attack. |
| 105 CFU/50 μL treatment group |
The fourth mammary gland pair was injected with 50 μL of a bacterial suspension of 105 CFU/50 μL and killed after 24 h of attack. |
Table 2.
Dosage regimen.
| Group |
Method of administration |
Dosing |
| Blank control group |
/ |
No treatment |
| Physiological saline treatment group |
Infusion feeding |
1.5mg/(Kg.BW) saline, 2 times/d for 7d |
| Antibacterial peptide treatment group |
Infusion feeding |
1.5mg/(Kg.BW) antimicrobial peptide extract, 2 times/d, 7d continuous administration |
| Antibiotic (CPFX) treatment group |
Infusion feeding |
1mg/(Kg.BW) CPFX, 2 times/d for 7d |
Table 3.
Concentration of maggot Antimicrobial peptides by the different treatment.
Table 3.
Concentration of maggot Antimicrobial peptides by the different treatment.
| Group |
Concentration (μg/ml) |
| Uninduced group |
22.23±0.18 |
| S.aureus induction group |
25.36±1.91* |
Table 4.
diameter of inhibition zone at different groups.
Table 4.
diameter of inhibition zone at different groups.
| Group |
Diameter of inhibition circle (mm) |
Antibacterial activity |
| Uninduced group |
13.82±0.79 |
Moderately susceptible |
| S.aureus induction group |
19.97±0.65* |
Highly susceptible |
| Antibiotic (CPFX) group |
22.21±0.75* |
Highly susceptible |
Table 5.
The Minimal inhibitory concentration of AMPs and CPFX.
Table 5.
The Minimal inhibitory concentration of AMPs and CPFX.
| Concentration (mg/L) |
S.aureus |
Concentration (mg/L) |
S.aureus |
| AMPs |
|
CPFX |
|
| 5.0 |
- |
5.0 |
- |
| 4.5 |
- |
4.5 |
- |
| 4.0 |
- |
4.0 |
- |
| 3.5 |
- |
3.5 |
- |
| 3.0 |
- |
3.0 |
- |
| 2.5 |
- |
2.5 |
- |
| 2.0 |
- |
2.0 |
- |
| 1.5 |
+ |
1.5 |
- |
| 1.0 |
+ + |
1.0 |
+ |
| 0.5 |
+ + |
0.5 |
+ + |
| 0 |
+ + |
0 |
+ + |
Table 6.
Results of bacterial count, incidence of mastitis, and death of mice in breast tissue.
Table 6.
Results of bacterial count, incidence of mastitis, and death of mice in breast tissue.
| Group |
S.aureus count (log10 CFU/g) |
Mastitis prevalence % |
Mouse mortality % |
| Blank control group |
- |
0 |
0 |
| Physiological saline group |
- |
0 |
0 |
| 102 CFU/50μl treatment group |
1.81±1.34** |
40 |
0 |
| 103 CFU/50μl treatment group |
4.09±0.26** |
100 |
0 |
| 104 CFU/50μl treatment group |
6.24±0.84** |
100 |
60 |
| 105 CFU/50μl treatment group |
7.51±0.33** |
100 |
100 |
Table 7.
Breast tissue Tumor necrosis factor-α (TNF-α) content.
Table 7.
Breast tissue Tumor necrosis factor-α (TNF-α) content.
| Group |
TNF-α content (pg/ml) |
| Blank control group |
25.57±2.29 |
| Physiological saline group |
26.06±1.35 |
| 102 CFU/50μl treatment group |
46.10±0.81** |
| 103 CFU/50μl treatment group |
75.86±2.87** |
| 104 CFU/50μl treatment group |
144.95±6.60** |
| 105 CFU/50μl treatment group |
159.86±6.51** |
Table 8.
Breast tissue Tumor necrosis factor-α (TNF-α) content.
Table 8.
Breast tissue Tumor necrosis factor-α (TNF-α) content.
| Group |
TNF-α levels in breast tissue (pg/ml) |
| 3d |
5d |
7d |
| Blank control group |
25.01±1.59Aa |
25.14Aa±0.64Aa |
24.94Aa±0.65Aa |
| Physiological saline treatment group |
163.57±2.47B |
190.92±3.48E |
- |
| Antibacterial peptide treatment group |
127.61±5.18C |
93.24±3.54F |
39.28±2.67Ab |
| Antibiotic treatment group |
96.13±2.20D |
63.84±2.65G |
31.6±2.55Ac |
Table 9.
Results of bacterial count, incidence of mastitis, and death of mice in breast tissue.
Table 9.
Results of bacterial count, incidence of mastitis, and death of mice in breast tissue.
| Group |
S.aureus count (log10 CFU/g) |
Mortality % |
Cure rate % |
| 3d |
5d |
7d |
| Blank control group |
- |
- |
- |
0 |
- |
| Physiological saline treatment group |
8.24±0.35 |
9.37±0.16 |
- |
100 |
0 |
| Antibacterial peptide treatment group |
6.06±0.24 |
3.79±0.26 |
1.93±0.31 |
0 |
40 |
| Antibiotic treatment group |
4.95±0.28 |
3.39±0.43 |
1.54±0.57 |
0 |
80 |
|
Disclaimer/Publisher’s Note: The statements, opinions and data contained in all publications are solely those of the individual author(s) and contributor(s) and not of MDPI and/or the editor(s). MDPI and/or the editor(s) disclaim responsibility for any injury to people or property resulting from any ideas, methods, instructions or products referred to in the content. |
© 2023 by the authors. Licensee MDPI, Basel, Switzerland. This article is an open access article distributed under the terms and conditions of the Creative Commons Attribution (CC BY) license (http://creativecommons.org/licenses/by/4.0/).